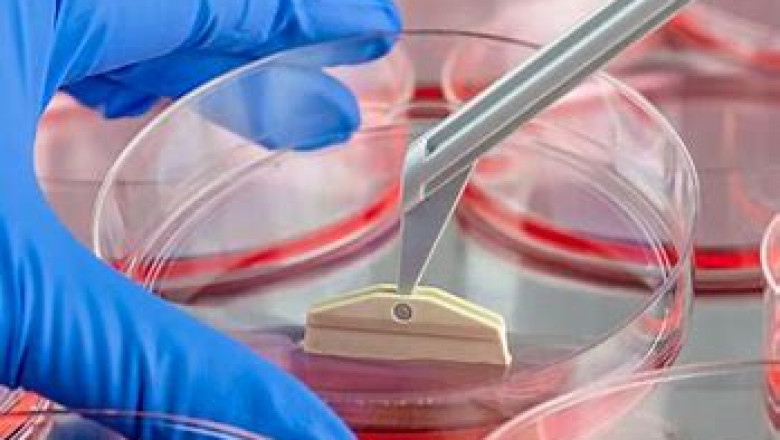

views
The Cell Therapy Instrument Market research report provides the latest industry data, growth, key segments and future trends on the basis of the detailed study. This market report also allows you to identify the future opportunity and growth rate of the leading segment based on regions and countries.
The report also covers detailed competitive landscape including company profiles of key players operating in the global market. The key players in the cell therapy instrument market include BD Bioscience, Danaher (Beckman Coulter, Inc.), General Electric, Lonza, Merck Kgaa, MiltenyiBiotec, Sartorius AG, Stemcell Technologies Inc., Terumo Corporation and Thermo Fisher Scientific Inc. among others. An in-depth view of the competitive outlook includes future capacities, key mergers & acquisitions, financial overview, partnerships, collaborations, new product launches, new product developments and other developments with information in terms of H.Q.
Get more information on "Global Cell Therapy Instrument Market Research Report" by requesting FREE Sample Copy athttps://www.valuemarketresearch.com/contact/cell-therapy-instrument-market/download-sample
Market Dynamics
The market is likely to witness growth on account of rising in funding for promoting cell-based research from government and private organizations. Increasing collaboration between smaller organizations with prominent players for niche therapeutic purpose is fueling the market growth. Increase in count of cancer cell-based therapy clinical trials to curb cancer proliferation is also boosting the market growth. Despite this, the high cost of cell-based research with low success rate is likely to hinder the market growth.
This detailed market study is centered on the data obtained from multiple sources and is analyzed using numerous tools including porter’s five forces analysis, market attractiveness analysis and value chain analysis. These tools are employed to gain insights of the potential value of the market facilitating the business strategists with the latest growth opportunities. Additionally, these tools also provide a detailed analysis of each application/product segment in the global market of cell therapy instrument.
Browse Global Cell Therapy Instrument Market Research Report with detailed TOC athttps://www.valuemarketresearch.com/report/cell-therapy-instrument-market
Market Segmentation
The broad cell therapy instrument market has been sub-grouped into product, application, cell type and end-user. The report studies these subsets with respect to the geographical segmentation. The strategists can gain a detailed insight and devise appropriate strategies to target specific market. This detail will lead to a focused approach leading to identification of better opportunities.
By Product
- Consumables
- Equipment
- Software
By Application
- Cell Processing
- Cell Preservation Distribution & Handling
- Process Monitoring & Quality Control
By Cell Type
- Human Cells
- Animal Cells
By End-User
- Life Science Companies
- Research Institutes
Regional Analysis
Furthermore, the report comprises of the geographical segmentation, which mainly focuses on current and forecast demand for cell therapy instrument in North America, Europe, Asia Pacific, Latin America, and Middle East & Africa. The report further focuses on demand for individual application segments in all the regions.
Purchase complete Global Cell Therapy Instrument Market Research Report athttps://www.valuemarketresearch.com/contact/cell-therapy-instrument-market/buy-now
About Us:
Value Market Research was established with the vision to ease decision making and empower the strategists by providing them with holistic market information.
We facilitate clients with syndicate research reports and customized research reports on 25+ industries with global as well as regional coverage.
Contact:
Value Market Research
401/402, TFM, Nagras Road, Aundh, Pune-7.
Maharashtra, INDIA.
Tel: +1-888-294-1147
Email: sales@valuemarketresearch.com
Website: https://www.valuemarketresearch.com












